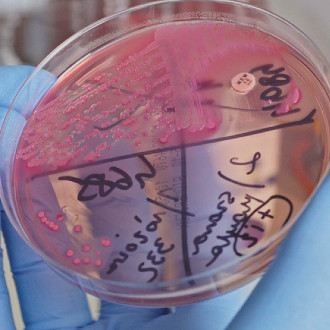

- Dowiedz się więcej
Biologia i Chemia po akademicku
Serdecznie zapraszamy wszystkich uczniów szkół średnich do udziału w bezpłatnych zajęciach z biologii i chemii na Uniwersytecie Medycznym w Białymstoku!
Aktualności


Podsumowanie Projektu Teraz już wiem-cykl filmow edukacyjnych
03.08.2023 15:22Autor: Administrator UMB
Podsumowanie szóstego quizu pt. Badania laboratoryjne w praktyce
23.06.2023 08:58Autor: Administrator UMB
Badania laboratoryjne w praktyce - szósty odcinek serii "Teraz już wiem" już dostępny!
20.06.2023 11:38Autor: Administrator UMB
Premiera szóstego odcinka serii "Teraz już wiem- cykl filmów edukacyjnych" już 20 czerwca!
16.06.2023 08:23Autor: Administrator UMB
Plebiscyt internetowy na film edukacyjny z cyklu "Teraz już wiem" został rozstrzygnięty!
04.04.2023 08:57Autor: Administrator UMB

